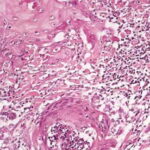

Kerato acanthoma =القرنوم الشائك
Keratoacanthoma
Keratoacanthoma is a common epithelial tumor of the skin characterized by rapid growth, histopathologic features similar to those of cutaneous squamous cell carcinoma, and a certain tendency toward spontaneous regression. The exact nosology and classification of keratoacanthoma are a matter of debate. Some authors regard keratoacanthoma as a benign cutaneous tumor that is the prototype of a “pseudomalignant” tumor of the skin, whereas others maintain that it is a malignant neoplasm and should be regarded as a variant of cutaneous squamous cell carcinoma.
The authors of this chapter believe that keratoacanthoma represents a peculiar variant of squamous cell carcinoma, based on the rare but wellknown potential for distant metastases, and the capability for local destruction of important structures.
EPIDEMIOLOGY
The exact incidence of keratoacanthoma is unknown. The tumor is more frequent in light-skinned persons, and rarer in dark-skinned and Japanese persons. The relative frequency in comparison with squamous cell carcinoma of the skin is controversial, but most studies show a lower incidence of keratoacanthoma than of squamous cell carcinoma. Discordant results may be explained, at least in part, by differences in classification of these lesions.
Studies on gender distribution reveal that both sexes are affected equally, possibly with a slight predilection for men. Keratoacanthoma occurs mostly in adult life, with a peak between the ages of 55 and 65 years; it has been observed rarely in younger patients. The familial type of keratoacanthoma occurs often during adolescence, and a neonatal case has been reported. Although the incidence was thought to remain stable after a peak in the sixth decade, a study conducted in a defined population in Hawaii revealed that keratoacanthoma increases with age, in a fashion similar to that observed for cutaneous basal and squamous cell carcinomas.
Relationship to Squamous Cell Carcinoma
The authors of earlier reports considered keratoacanthoma to be a form of epithelial cancer of the skin, and named it accordingly. However, since the introduction of the concept of keratoacanthoma as a benign, self-healing neoplasm distinct from squamous cell carcinoma, the relationship between these two epithelial tumors has been the subject of debate. In their paper published in 1950, Rook and Whimster wrote, “This disease is evidently not cancerous or precancerous.”2 On the other hand, Kwittken, in 1975, stated, “I have come to the firm conclusion that all of these lesions are malignancies and that the formerly accepted concept of a self-healing squamous cell carcinoma of the skin is a correct one,” and in 1979, even Rook amended his initial concept by writing, “…transformation from keratoacanthoma to squamous cell carcinoma occurs frequently.”11 Cases of typical keratoacanthoma with metastases have been observed,12 and four possible explanations for this phenomenon have been suggested: an initial misdiagnosis of keratoacanthoma; the presence of both keratoacanthoma and squamous cell carcinoma in the same lesion; the malignant transformation of keratoacanthoma into squamous cell carcinoma; and, finally, the possibility that keratoacanthoma may be a peculiar variant of squamous cell carcinoma.13 The debate is not settled yet, and some authors still maintain that keratoacanthoma represents a benign epithelial tumor, distinct from squamous cell carcinoma,14 whereas others hold that it is a variant of squamous cell carcinoma with tendency to spontaneous regression, but with the potential for giving rise to lethal distant metastases.15 Two studies of large numbers of cases highlighted the impossibility of reliably differentiating keratoacanthoma from squamous cell carcinoma using histopathologic criteria alone.16,17 Recently, a patient under infliximab therapy developed multiple squamous cell carcinomas as well as keratoacanthomas, suggesting a common pathogenetic pathway on immunosuppression.18 In addition, multiple keratoacanthomas and multiple squamous cell carcinomas may be observed at the same skin site (“field cancerization”) . Keratoacanthomas have a higher proliferation rate than squamous cell carcinomas.19 Other investigations pointed at similarities among squamous cell carcinoma and keratoacanthoma in the expression of oncogenetic and cell-cycle-regulating proteins as well as regarding the presence of trisomy 7 in a subset of tumors in both groups, thus suggesting a close relationship between these two entities.20-25 On the other hand, studies on loss of heterozygosity, on expression of angiotensin type 1 receptor and of desmogleins 1 and 2, on adhesion molecules vascular cellular adhesion molecule and intercellular adhesion molecule, on telomerase activity, on apoptotic and cell adhesion markers, and on chromosomal aberrations assessed by comparative genomic hybridization showed differences among keratoacanthomas and squamous cell carcinomas.26-32 Using different molecular techniques, both similarities and differences between keratoacanthoma and squamous cell carcinoma have been recently demonstrated.33 In short, at present, and in spite of the great amount of clinical and experimental data collected over the decades, the exact nosology of keratoacanthoma is not clear, and the term abortive malignancy has been proposed.34
ETIOLOGY AND PATHOGENESIS
Different etiologic factors are probably involved in the development of keratoacanthomas in different patients, and it seems likely that these different factors act synergistically to induce the onset of a lesion in a given patient. The role of chronic ultraviolet (UV) light exposure in the etiology of keratoacanthoma is well documented by the frequent occurrence on sun-exposed areas, as well as by the presence of keratoacanthomas in patients with xeroderma pigmentosum and after prolonged psoralen and UVA light (PUVA) treatment. In patients with multiple keratoacanthomas, PUVA treatment accelerates the development of the tumors, but the risk for keratoacanthoma after therapy with PUVA seems lower than that for squamous or basal cell carcinoma. An etiologic link to UV light has been confirmed also by experimental studies in mice.
The relationship of keratoacanthoma to chemical carcinogens has been well documented in humans and in several animals.37 In fact, the incidence of keratoacanthoma is higher in industrial towns, and among industrial workers coming in contact with pitch, mineral oils, and tar. Chemical carcinogens may act in conjunction with UV rays to induce the onset of keratoacanthomas. Smokers seem also to be more affected than nonsmokers.37
Keratoacanthomas have been reported at the site of injury. The association with trauma is also documented by the report of cases occurring after skin grafting, at both the donor and the recipient sites, and at the site of arterial puncture and vaccination.38, 39, 40 The role of human papillomavirus (HPV) remains controversial. Recently, evidence of HPV infection was documented by the highly sensitive polymerase chain reaction technique,41,42 but other studies failed to detect viral material within lesions of keratoacanthoma.43 Some studies found an association with HPV-25, and HPV-19 and HPV-48 have been isolated in a lesion arising in a human immunodeficiency virus (HIV) patient.44,45 Several other types of HPV have been linked to keratoacanthoma, including types 6, 9, 14, 16, 19, 35, 37, 58, and 61.
Genetic factors probably play a major role in the familial type of keratoacanthoma. In the other variants of keratoacanthoma, it seems likely that genetic aspects interplay with other etiologic factors (i.e., UV rays, trauma, infections) by providing the genetic predisposition for the development of the tumor. Keratoacanthomas are commonly observed in patients with Muir-Torre syndrome, suggesting that the genetic defect(s) of this syndrome also plays a role in the development of keratoacanthoma.46, 47, 48, 49 In addition, keratoacanthomas have been observed in patients affected by a variety of skin diseases including psoriasis, lupus erythematosus, lichen planus, atopic dermatitis, herpes zoster, acne conglobata, and pemphigus foliaceus, among others.38
Keratoacanthomas also have been observed in patients under immunosuppression as a result of bone marrow transplantation, cyclosporine treatment, or infection with HIV, thus suggesting that immunosuppression may play an etiologic role in some cases. In these patients, most lesions of keratoacanthoma tested for presence of HPV proved positive, suggesting that immunosuppression may contribute by decreasing the immune response against possible causative agents.50 Similarly, UV light may act not only by direct carcinogenesis, but also by virtue of the local immunosuppression caused by sun exposure .
Little is known about the pathogenesis of keratoacanthoma, and about the exact mechanisms of regression in the absence of any treatment. Studies on p53 oncoprotein expression and p53 gene mutations revealed expression of p53 oncoprotein in the great majority of tested cases, and association with a point mutation in the p53 gene in slightly more than 10 percent of these cases, suggesting a possible role of p53 gene in the development of some keratoacanthomas.
Multiple keratoacanthomas of the Ferguson-Smith type show a familial distribution and are transmitted in an autosomal dominant fashion. The gene responsible for this syndrome is localized to chromosome 9q. The majority of the cases have been described in some Scottish families, and in these patients, the syndrome is thought to be caused by a single genetic mutation that occurred before 1790.
CLINICAL FINDINGS
Keratoacanthomas occur mostly on sun-exposed skin of the face, forearms, and dorsal aspects of the hands . Actinic damage is commonly found in the surrounding skin. In most instances, they are located on hairy skin, but lesions with similar clinicopathologic aspects have been described in the oral cavity, the subungual region, the genital mucosa, and the conjunctiva.
The stereotypic example of keratoacanthoma is represented by a solitary lesion growing rapidly within a few weeks, and subsequently showing a slow involution over a period of a few months. Three clinical stages have been described: proliferative, mature, and resolving.38 Lesions in the proliferative stage are rapidly enlarging erythematous papules that grow up to a dimension of 1 to 2 cm or more. In this stage, the lesions are symmetric and firm and show a smooth surface. In the mature stage there are symmetric, firm, erythematous or skin-colored nodules with a central keratotic core (see Fig. 117-2). The central part can appear crateriform if the keratotic core is removed. Ghadially divided mature keratoacanthomas into three main morphologic types: type 1, or bud-shaped; type 2, or dome-shaped;
and type 3, or berry-shaped.39 Regressing lesions are characterized by a keratotic, partly necrotic nodule that becomes progressively flat upon elimination of the keratotic plug, eventually leaving a hypopigmented scar (Fig. 117-3; Box 117-1).
Systemic Associations
Keratoacanthomas may be associated with multiple internal cancers in patients with Muir-Torre syndrome and the related hereditary nonpolyposis colorectal cancer syndrome. Patients with multiple keratoacanthomas should always be evaluated for the presence of typical traits of Muir-Torre syndrome, where cutaneous sebaceous tumors and low-grade visceral malignancies can be observed (most commonly carcinomas of the gastrointestinal tract, but also carcinomas of the lung and genitourinary system, and, occasionally, colonic polyps). It has been suggested that at least some of the patients with multiple keratoacanthomas of the Ferguson-Smith type may have an incomplete form of the Muir-Torre syndrome.
Keratoacanthomas may also occur in patients with xeroderma pigmentosum and, rarely, in patients with lymphomatoid papulosis .
Clinical Differential Diagnosis of Keratoacanthoma
Most Likely
- · Squamous cell carcinoma
Consider
- · Well-developed tumors
- o Common warts
- o Molluscum contagiosum
- o Prurigo nodularis
- o Metastatic carcinoma
- · Regressing tumors
- o Regressing lesions of lymphomatoid papulosis
- o Regressing lesions of anaplastic large cell lymphoma
- o Amelanotic melanoma
Variants
Several variants of keratoacanthoma have been described, and different morphologic types of keratoacanthoma have been observed in a single patient.
Giant Keratoacanthoma
In some instances, keratoacanthomas may reach dimensions of several centimeters (see eFig. 117-3.1 in on-line edition), and even a tumor reaching 15 cm in its diameter has been observed. Giant keratoacanthomas show a predilection for the nose and the dorsum of the hands. In some cases, the growth of the tumor may be associated with destruction of underlying tissues .
Keratoacanthoma Centrifugum Marginatum
Keratoacanthoma centrifugum marginatum is characterized by multiple tumors growing on a localized area, usually on the face, trunk, or extremities . Tumors are annular, polycyclic, or circular in morphology. The area affected may reach 20 cm in diameter, and resolution may be slower than in solitary keratoacanthoma.
Multiple Keratoacanthomas of the Ferguson-Smith Type
The Ferguson-Smith type is a familial form of keratoacanthoma that affects both sexes with approximately equal severity, which is characterized by the appearance of multiple, sometimes hundreds of keratoacanthomas, each with the clinicopathologic aspects of a solitary keratoacanthoma. The disorder is inherited in an autosomal-dominant manner, and the majority of the cases have been described in a few Scottish families. Patients develop keratoacanthomas during adolescence and early adulthood, but onset during childhood is not infrequent. It has been suggested that at least some of these patients may have an incomplete form of the Muir-Torre syndrome.
Generalized Eruptive Keratoacanthomas of Grzybowski
Keratoacanthomas of Grzybowski is a variant characterized by the presence of hundreds to thousands of tiny follicular keratotic papules disseminated all over the body, with predominance on sun-exposed areas. Facial involvement is usually severe, and coalescence of lesions around the eyes may cause ectropion. The mucosal regions (oral, genital) may be affected, whereas palms and soles are usually not involved. The age of onset is similar to that of solitary keratoacanthoma, and clustering in families has not been observed.
Subungual Keratoacanthoma
Subungual keratoacanthoma (see eFig. 117-5.1 in on-line edition) differs from the other types of keratoacanthoma by being persistent and often causing destruction of the underlying bone. The tumor originates in the distal nail bed, separating the nail plate from the nail bed, and can grow rapidly causing destruction of the entire phalanx.
Keratoacanthoma of the Mucosal Regions
Keratoacanthomas have been described in the oral mucosa, the conjunctiva, the nasal mucosa, and the genital mucosa. In fact, involvement of the oral and genital mucosa is common in the generalized eruptive keratoacanthomas of the Grzybowski type. Keratoacanthomas arising on mucosal regions, especially on the oral mucosa, present clinically as slowly growing crateriform lesions that tend to persist for many months or years.
PATHOLOGY
The histopathologic diagnosis of keratoacanthoma rests mainly on the silhouette of the tumor as assessed at scanning magnification; inadequate specimens (i.e., punch biopsies, shave biopsies, curettage) do not allow a diagnosis and differentiation from squamous cell carcinoma. Two large studies on the histopathologic criteria for diagnosis of keratoacanthoma emphasized the overlapping features between this tumor and squamous cell carcinoma, which render differentiation very difficult or even impossible in given cases.
The histopathologic features of keratoacanthoma depend on the stage of evolution of the tumor. In early, proliferative lesions, the epithelium is markedly hyperplastic, and the central keratotic plug is not as pronounced as in fully developed lesions. The lesion has an overall symmetric aspect . Although atypical cells do not represent the majority of the cells in typical keratoacanthoma, there may be atypical keratinocytes and mitoses, especially at the lower margin of the tumor. Nests of epithelial cells may detach from the main tumor mass and be found in the superficial reticular dermis. Fully developed, mature lesions are characterized by a large central core of keratin surrounded by a well-differentiated proliferation of squamous epithelium that in some cases may resemble squamous cell carcinoma . The epidermis at both sides of the central core extends over the keratotic area in a fashion that has been described as “lipping” or “buttressing,” giving a distinct crateriform appearance to the lesion. Nests and strands of keratinocytes may be found apart from the main bulk of the tumor but usually do not extend lower than the level of sweat glands .
Cytomorphologically, large keratinocytes with eosinophilic cytoplasm are commonly observed, together with atypical cells and mitoses . An inflammatory infiltrate containing lymphocytes, plasma cells, histiocytes, eosinophils, and neutrophils is a common feature, and in some instances may be conspicuous. Neurotropism and even vascular invasion can be observed in otherwise typical keratoacanthomas, but the prognosis does not seem to be affected by these histopathologically worrisome features .
PROGNOSIS
Solitary keratoacanthoma behaves as a benign tumor in the majority of the cases, but lymph node and visceral metastases have been observed in a small number of patients. Central facial keratoacanthoma may behave aggressively. There are no clear-cut features to predict the biologic behavior of a given tumor, but persistent and recurrent lesions should be managed by complete surgical excision. Histopathologic features that are associated with a poor prognosis in common squamous cell carcinoma, such as neurotropism and vascular invasion,
do not seem to have prognostic implications in keratoacanthomas. Ungual keratoacanthomas do not show a tendency to spontaneous regression and often are the cause of massive bone destruction. In spite of aggressive local behavior, however, distant metastases have not been observed in ungual and mucosal types of keratoacanthoma.
Histopathologic Differential Diagnosis of Keratoacanthoma
Most Likely
- · Squamous cell carcinoma
Regressing Tumors: Consider
- · Other regressing epithelial tumors
- · Regressing lesions of lymphomatoid papulosis
- · Regressing lesions of anaplastic large cell lymphoma
TREATMENT
Keratoacanthomas show a tendency to spontaneous regression, and, in typical cases, an acceptable therapeutic option may be to adopt the so-called watchful waiting strategy. However, because of the uncertainty regarding the exact nosology of this tumor, as well as the difficulty to differentiate it clinically from squamous cell carcinoma, complete conservative excision is advised in most cases, especially in those of solitary keratoacanthoma and in keratoacanthoma of the face. Removal by shave excision below the base to preserve architecture for diagnostic purposes followed by electrodesiccation and curettage are being increasingly performed for keratoacanthoma. Punch biopsies never allow differentiation of keratoacanthoma from well-differentiated squamous cell carcinoma and should be avoided. For diagnostic purposes, a longitudinal biopsy that includes normal skin at both margins of the lesion as well as the underlying fat tissues is acceptable. Mohs micrographic surgery has been adopted for difficult cases such as recurrent lesions, lesions in the central facial area, giant lesions, or lesions of keratoacanthoma centrifugum marginatum that may cover a large area of the body. Therapy by laser vaporization, electrodesiccation, and cryosurgery with liquid nitrogen does not allow the histopathologic verification of the clinical diagnosis.
Treatment for Keratoacanthoma
FIRST LINE
- · Complete surgical excision
SECOND LINE
- · Curettage followed by electrodesiccation
- · Radiotherapy
- · Intralesional chemotherapeutic agents, intralesional interferon
- · Oral retinoids
- · Photodynamic therapy
- ·
Keratoacanthomas have been treated by radiotherapy (electron beam, or the voltage radiation, superficial x-ray) with excellent results. This type of treatment is particularly indicated for lesions that can be difficult to manage surgically. Intralesional instillation of chemotherapeutic agent (methotrexate, bleomycin, and 5-fluorouracil) has also proved therapeutically successful,and 5-fluorouracil has been applied also topically. Some keratoacanthomas have been treated by intralesional injection of interferon-α 2a,66,67 and others have been successfully treated with intralesional application of triamcinolone. Successful topical treatment has been performed with podophyllin, either alone or in combination with other treatment modalities. However, podophyllin is also capable of inducing keratoacanthomas. Multiple keratoacanthomas have been treated successfully with oral retinoids in several cases, but larger studies have not been performed. Systemic treatments include chemotherapy with methotrexate, cyclophosphamide, or 5-fluorouracil.
A further treatment option for keratoacanthoma of both solitary and multiple types is represented by photodynamic therapy with δ-aminolevulinic acid . The treatment is simple and has been shown to achieve good therapeutic and cosmetic results. Topical imiquimod has been reported to induce regression of keratoacanthoma.
▪ PREVENTION
Preventive measures against the development of keratoacanthomas are similar to those applied for basal and squamous cell carcinoma of the skin. In predisposed subjects (i.e., fair skin, history of multiple actinic keratoses, basal and/or squamous cell carcinomas, Muir-Torre syndrome), avoidance of direct sun exposure should be achieved, and skin protection creams applied.